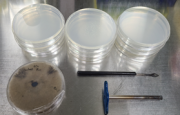
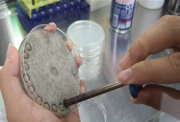
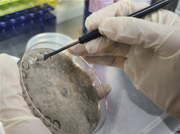
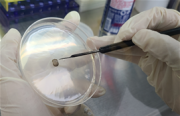
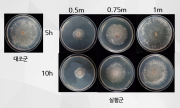

파일 목록
이 특수 문서는 모든 올려진 파일을 보여줍니다.
처음 문서 |
이전 문서 |
다음 문서 |
마지막 문서 |
| 날짜 | 이름 | 섬네일 | 크기 | 설명 | 버전 |
|---|---|---|---|---|---|
| 2018년 6월 13일 (수) 10:23 | Arm decoupling.PNG (파일) | 10 KB | 1 | ||
| 2018년 6월 13일 (수) 10:24 | Arm generalsol.PNG (파일) |  |
25 KB | 1 | |
| 2018년 6월 13일 (수) 10:41 | Arm error.PNG (파일) | 45 KB | 1 | ||
| 2018년 6월 14일 (목) 08:28 | Arm grid.PNG (파일) |  |
13 KB | 1 | |
| 2018년 6월 14일 (목) 08:28 | Arm newtest.PNG (파일) |  |
25 KB | 1 | |
| 2018년 6월 14일 (목) 09:01 | Arm newtest2.PNG (파일) |  |
25 KB | 1 | |
| 2020년 6월 13일 (토) 00:53 | App insidemode screenshot.jpg (파일) |  |
249 KB | 앱 실내모드 스크린샷 | 1 |
| 2020년 6월 13일 (토) 00:55 | App outsidemode screenshot.jpg (파일) |  |
146 KB | 앱 실외모드 스크린샷 | 1 |
| 2020년 6월 16일 (화) 07:29 | 개발일정표.PNG (파일) |  |
126 KB | 99-1=0, 개발일정표 | 1 |
| 2020년 6월 16일 (화) 08:14 | 99-1=0 개발일정표.png (파일) |  |
57 KB | 99-1=0_개발일정표 | 1 |
| 2020년 6월 16일 (화) 08:22 | 99-1=0 세부개발일정표.png (파일) |  |
57 KB | 99-1=0 세부개발일정표 | 1 |
| 2020년 6월 16일 (화) 08:24 | 99-1=0 최근4년간국내미세먼지수치.png (파일) |  |
142 KB | 1 | |
| 2020년 6월 16일 (화) 08:26 | 99-1=0 최근전세계적바이러스주기.png (파일) | 35 KB | 1 | ||
| 2020년 6월 16일 (화) 08:28 | 99-1=0 UV자외선을이용한살균 미세먼지정화과정.png (파일) |  |
77 KB | 1 | |
| 2020년 6월 16일 (화) 08:39 | 99-1=0 시스템구성도.png (파일) |  |
314 KB | 2 | |
| 2020년 6월 16일 (화) 08:57 | 99-1=0 동작시나리오.png (파일) |  |
24 KB | 1 | |
| 2020년 6월 16일 (화) 09:03 | 99-1=0 무드등모드3D설계.png (파일) |  |
58 KB | 1 | |
| 2020년 6월 16일 (화) 09:04 | 99-1=0 자외선살균모드3D.png (파일) |  |
61 KB | 1 | |
| 2020년 6월 16일 (화) 09:07 | 99-1=0 모터설계.png (파일) |  |
38 KB | 1 | |
| 2020년 6월 16일 (화) 09:07 | 99-1=0 모터구현.png (파일) |  |
122 KB | 1 | |
| 2020년 6월 16일 (화) 09:11 | 99-1=0 슬라이드핀설계.png (파일) |  |
26 KB | 1 | |
| 2020년 6월 16일 (화) 09:15 | 99-1=0 LED각도설계.png (파일) |  |
28 KB | 1 | |
| 2020년 6월 16일 (화) 09:17 | 99-1=0 실제구현1.png (파일) |  |
254 KB | 1 | |
| 2020년 6월 16일 (화) 09:20 | 99-1=0 세균실험준비1.png (파일) | |
122 KB | 1 | |
| 2020년 6월 16일 (화) 09:20 | 99-1=0 세균실험준비2.png (파일) |  |
112 KB | 1 | |
| 2020년 6월 16일 (화) 09:21 | 99-1=0 세균실험준비3.png (파일) |  |
80 KB | 1 | |
| 2020년 6월 16일 (화) 09:21 | 99-1=0 세균실험준비4.png (파일) |  |
64 KB | 1 | |
| 2020년 6월 16일 (화) 09:25 | 99-1=0 세균실험과정1.png (파일) | |
133 KB | 1 | |
| 2020년 6월 16일 (화) 09:25 | 99-1=0 세균실험과정2.png (파일) | |
117 KB | 1 | |
| 2020년 6월 16일 (화) 09:25 | 99-1=0 세균실험과정3.png (파일) | |
122 KB | 1 | |
| 2020년 6월 16일 (화) 09:26 | 99-1=0 세균실험과정4.png (파일) |  |
104 KB | 1 | |
| 2020년 6월 16일 (화) 09:30 | 99-1=0 세균실험과정5.png (파일) |  |
129 KB | 1 | |
| 2020년 6월 16일 (화) 09:31 | 99-1=0 세균실험과정6.png (파일) |  |
123 KB | 1 | |
| 2020년 6월 16일 (화) 09:42 | 99-1=0 역할분담.png (파일) |  |
17 KB | 1 | |
| 2020년 6월 16일 (화) 09:47 | 99-1=0 미구현내용.png (파일) | 10 KB | 1 | ||
| 2020년 6월 16일 (화) 09:49 | 99-1=0 평가항목.png (파일) |  |
27 KB | 1 | |
| 2020년 6월 16일 (화) 22:12 | 99-1=0 목적계통도.PNG (파일) |  |
113 KB | 1 | |
| 2020년 6월 16일 (화) 22:28 | 99-1=0 개발용이성.PNG (파일) | 28 KB | 1 | ||
| 2020년 6월 16일 (화) 22:54 | 99-1=0 제어회로도1.PNG (파일) |  |
260 KB | 1 | |
| 2020년 6월 17일 (수) 02:25 | 99-1=0 실행결과.PNG (파일) |  |
173 KB | 1 | |
| 2020년 6월 17일 (수) 02:26 | 99-1=0 역할분담.PNG (파일) |  |
88 KB | 1 | |
| 2020년 6월 17일 (수) 02:28 | Slide.jpg (파일) |  |
251 KB | 1 | |
| 2020년 6월 17일 (수) 02:32 | 99-1=0 내부회로도2.jpg (파일) |  |
306 KB | 1 | |
| 2020년 6월 17일 (수) 02:38 | 99-1=0 사각기둥.jpg (파일) |  |
169 KB | 1 | |
| 2020년 6월 17일 (수) 03:02 | 99-1=0 Mood.jpg (파일) |  |
261 KB | 1 | |
| 2020년 6월 17일 (수) 03:03 | 99-1=0 완성본.jpg (파일) |  |
180 KB | 1 | |
| 2020년 6월 18일 (목) 21:45 | 시스템구성도.JPG (파일) |  |
81 KB | 1 | |
| 2020년 6월 18일 (목) 21:46 | 시나리오.JPG (파일) | 25 KB | 1 | ||
| 2020년 6월 19일 (금) 03:47 | 99-1=0 Aspergillus sp.PNG (파일) | |
685 KB | 2 | |
| 2020년 6월 19일 (금) 03:47 | 99-1=0 Cladosporium sp.PNG (파일) |  |
687 KB | 2 |
처음 문서 |
이전 문서 |
다음 문서 |
마지막 문서 |